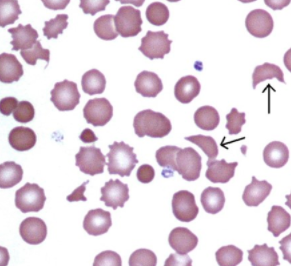

A 23 year old lady who presents with recurrent abscesses. Otherwise healthy. On examination she had four areas of abscesses, two of which on her arm. She was haemodynamically stable. Which antibiotic is likely to help this lady?
linezolid
A 23 year old lady who presents with recurrent abscesses. Otherwise healthy. On examination she had four areas of abscesses, two of which on her arm. She was haemodynamically stable. Which organism is most likely to cause this?
staph aureus
A 23 year old lady who presents with recurrent abscesses. Otherwise healthy. On examination she had four areas of abscesses, two of which on her arm. She was haemodynamically stable. Which toxin is likely to cause this presentation?
panton-valentine Leukocidin toxin
30 yr old iv drug user was admitted with jaundice. Investigations show the following, HBV surface antigen negative HBV core antibody positive HBV surface antibody positive HAV igM antibody positive
he has acute hepatitis A infection
This 28 year old man presents with a 3 week history of swallowing difficulties.
The most likely organism to cause this appearance is:

candida albicans
which of the following is an unlikely underlying cause for candida albicans infection:
a. HIV
b. Smoking
c. Proton pump inhibitors
d. Lymphoma
e. Inhaled steroid use
smoking
You are taking blood from an acutely ill HIV positive patient in the infection unit at midnight and you accidentally stab yourself with the needle.
What do you do first?
wash the wound and encourage bleeding
You are taking blood from an acutely ill HIV positive patient in the Infection unit at midnight and you accidentally stab yourself with the needle.
What is the highest risk of blood borne virus transmission?
a. Hepititis B
b. HIV
c. Hepatitis C
hep B
You have isolated E.coli from two sets of blood cultures taken on a jaundiced patient who was admitted in septic shock. Which of the following is a likely source?
a. Pneumonia
b. Osteomyelitis
c. Gastroenteritis
d. Biliary sepsis
e. Infective endocarditis
biliary sepsis
A 5 year old farmer’s daughter with the following:
History: –3 days ago developed diarrhoea –Worsened 2 Days ago –Blood PR for 24 Hours –Abdominal Pain –Reduced Urine Output
Examination: –HR 84, BP 150/95, T 36.50C –Tender Abdomen
Investigations Hb 95 (120-140) WBC 20 (4-10) Plat 90 (140-400) Urea 20 (3-7) Creat 450 (60-100)
What is the most likely infecting organism?
E. coli 0157
A 5 year old farmer’s daughter with the following:
History: –3 days ago developed diarrhoea –Worsened 2 Days ago –Blood PR for 24 Hours –Abdominal Pain –Reduced Urine Output
Examination: –HR 84, BP 150/95, T 36.50C –Tender Abdomen
Investigations Hb 95 (120-140) WBC 20 (4-10) Plat 90 (140-400) Urea 20 (3-7) Creat 450 (60-100)
Which antibiotic would you commence?
none
A 40 year old man with a background history of alcohol excess was admitted to hospital with 3 month history of significant weight loss, non productive cough and shortness of breath. He travels frequently with his work.

Chest auscultation only revealed a few basal crepititions, saturations were 92% on air. But he desaturates to 80% on minimal exertion.
Bloods -WCC 3.9, Platelets 100, CRP 23.
What is the most likely diagnosis?
pneumocystis jiroveci pneumonia
A 40 year old man with a background history of alcohol excess was admitted to hospital with 3 month history of significant weight loss, non productive cough and shortness of breath. He travels frequently with his work.
Chest auscultation only revealed a few basal crepititions, saturations were 92% on air. But he desaturates to 80% on minimal exertion.
Bloods -WCC 3.9, Platelets 100, CRP 23.
What is the underlying diagnosis?
HIV
A 40 year old man with a background history of alcohol excess was admitted to hospital with 3 month history of significant weight loss, non productive cough and shortness of breath. He travels frequently with his work.
Chest auscultation only revealed a few basal crepititions, saturations were 92% on air. But he desaturates to 80% on minimal exertion.
Bloods -WCC 3.9, Platelets 100, CRP 23.
What is the likely CD 4 Count?
<200
A 19 year old male with a 4 day history of fever of 40 degrees C, conjunctivitis, cough and coryzal symptoms •Appears unwell •New spreading macular rash visible on neck and face What is one of the most important first management steps for this patient?
isolate patient
A 19 year old male with a 4 day history of fever of 40 degrees C, conjunctivitis, cough and coryzal symptoms
•Appears unwell
New spreading macular rash visible on neck and face
Which is the likely mode of transmission if this is a case of measles?
droplet transmission
A 19 year old male with a 4 day history of fever of 40 degrees C, conjunctivitis, cough and coryzal symptoms
Appears unwell
New spreading macular rash visible on neck and face
Which of these are not Infection Prevention and Control precautions?
a. Single use equipment
b. 5 moments of hand hygiene
c. Personal protective equipment
d. Ice bath
e. Cohorting patients
ice bath
45 year old lady admitted with fever and right flank pain. On examination she has a GCS of 15, temperature of 39C, tachycardia of 115/min, blood pressure of 90/60. She has flank tenderness. Urine dipstick shows positive protein, blood and leucocytes. Which of these is a poor prognostic indicator?
a. High lactate
b. High temperature
c. Tachycardia
d. High white cell count
e. High CRP
high lactate
45 year old lady admitted with fever and right flank pain. On examination she has a GCS of 15, temperature of 39C, tachycardia of 115/min, blood pressure of 90/60. She has flank tenderness. Urine dipstick shows positive protein, blood and leucocytes.
You start the patient on the Sepsis 6 bundle. Which of these is NOT part of the bundle?
a. Measurement of lactate
b. Measurement of conscious level
c. Giving antibiotics
d. Measurement of urine output
e. Intravenous fluids
measurement of conscious level
45 year old lady admitted with fever and right flank pain. On examination she has a GCS of 15, temperature of 39C, tachycardia of 115/min, blood pressure of 90/60. She has flank tenderness. Urine dipstick shows positive protein, blood and leucocytes.
Despite giving 4 litres of intravenous fluids, her BP remains low and her lactate is 5.
What is your next course of action?
dicuss the patient w/ medical high dependency
A 70 year old diabetic lady is referred with a rapidly spreading cellulitis of her leg. She is in severe pain. Temp is 39C, pulse110/mini. BP:85/50. Right leg as shown.

What is the diagnosis?
necrotising fasciitis
A 70 year old diabetic lady is referred with a rapidly spreading cellulitis of her leg. She is in severe pain. Temp is 39C, pulse110/mini. BP:85/50.
You start this lady on Sepsis 6. What is the main priority in management of the lady?

urgent plastics review to do fasciotomy
A 70 year old diabetic lady is referred with a rapidly spreading cellulitis of her leg. She is in severe pain. Temp is 39C, pulse110/mini. BP:85/50.
what antibiotics would you start this patient on:
a. Benzyl penicillin
b. Flucloxacillin
c. Clindamycin
d. Gentamicin
e. All of the above

all of the above
A 45 year old gentleman presents to Acute Medicine with a few day history of fever and cough productive of green sputum. GCS 13 Resp rate 30/min Temp38 C Pulse 115 irreg BP 110/65 qSOFA = 2 All of these are criteria for qSOFA except
a. Pulse
b. Resp rate
c. GCS
d. Blood Pressure
pulse


